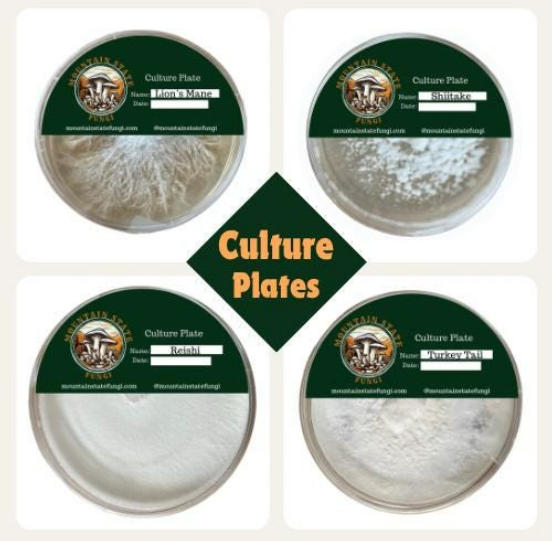

Drop us a line – we love talking fungi! Whether you have questions, need help choosing the right kit, or are ready to place an order, we’re just a message away. Reach out and let’s grow something amazing together!

Winter Rye Grain Spawn Bags
Our Winter Rye Grain Spawn starts with locally sourced seed, carefully soaked, boiled, and sterilized before being inoculated with aggressively colonizing mycelium. Heat-sealed for freshness and shipped ready to run — use it to inoculate bulk substrates or generate second-generation spawn bags for larger grows.
Commonly Available:
- Pearl Oyster
- Blue Oyster
- Italian Oyster
- Black Oyster
Available by Request:
- Shiitake
- Lion’s Mane
- Pink Oyster
- Golden Oyster

Master Mix Substrate Blocks
Skip the prep work. Our 5 lb Master Mix Blocks combine hardwood sawdust and soy hulls in a proven, high-yield substrate — sterilized, sealed, and ready for your grain spawn. Just inoculate, mix, and watch your mycelium take over.
Fresh Agar Plate Cultures
Our agar plate cultures are grown on sterilized potato dextrose agar (PDA) in crystal-clear polystyrene petri dishes — built for durability and easy handling in the lab.
Every plate is made to order using strict sterile technique in our in-house laboratory, ensuring you receive the freshest, highest-quality cultures possible. Each culture can be used to inoculate grain spawn or bulk substrate bags, produce liquid cultures, or generate additional plates to expand your library.

Mushroom Grow Kits
Our Mushroom Grow Kits are the perfect starting point for any home grower! Your block arrives ready to fruit right out of the box — no prep needed. Step-by-step instructions are included so you can get growing with confidence from day one!
Commonly Available:
- Pearl Oyster
- Blue Oyster
- Italian Oyster
- Black Oyster
Available by Request:
- Shiitake
- Lion’s Mane
- Pink Oyster
- Golden Oyster
All grow bags are made to order. 2.5lb bags are available for $15 per bag plus shipping.
T-Shirts
Nothing says “I’m a fungi” like our official Mountain State Fungi tee! Whether you’re out in the field, hitting the farmers market, or just repping West Virginia from your couch — we’ve got your size.
- Small, Medium, Large, XL — $25
- 2XL, 3XL — $30



